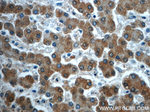
TMEM25 Antibody in Immunohistochemistry (Paraffin) (IHC (P))

Search
Proteintech
TMEM25 Polyclonal Antibody
{{$productOrderCtrl.translations['antibody.pdp.commerceCard.promotion.promotions']}}
{{$productOrderCtrl.translations['antibody.pdp.commerceCard.promotion.viewpromo']}}
{{$productOrderCtrl.translations['antibody.pdp.commerceCard.promotion.promocode']}}: {{promo.promoCode}} {{promo.promoTitle}} {{promo.promoDescription}}. {{$productOrderCtrl.translations['antibody.pdp.commerceCard.promotion.learnmore']}}
产品信息
24361-1-AP
种属反应
已发表种属
宿主/亚型
分类
类型
抗原
偶联物
形式
浓度
规格
纯化类型
保存液
内含物
保存条件
运输条件
产品详细信息
Immunogen sequence: LEPQIDGQT WAERALRENE RHAFTCRVAG GPGTPRLAWY LDGQLQEAST SRLLSVGGEA FSGGTSTFTV TAHRAQHELN CSLQDPRSGR SANASVILNV QFKPEIAQVG AKYQEAQGPG LLVVLFALVR ANPPANVTWI DQDGPVTVNT SDFLVLDAQN YPWLTNHTVQ LQLRSLAHNL SVVATNDVGV TSASLPAPGP SRHPSLISSD SNNLKLNNVR LPRENMSLPS NLQLNDLTPD SRAVKPADRQ MAQNNSRPEL LDPEPGGLLT SRGFIRLPVL GYIYRVSSVS SDEIWL (28-323 aa encoded by BC051841)
靶标信息
TMEM25 (Transmembrane Protein 25) is a Protein Coding gene. An important paralog of this gene is SIGLEC1.
仅用于科研。不用于诊断过程。未经明确授权不得转售。
生物信息学
蛋白别名: 0610039J01Rik; Transmembrane protein 25; unnamed protein product
基因别名: 0610039J01Rik; AI429491; TMEM25; UNQ2531/PRO6030
UniProt ID: (Human) Q86YD3, (Mouse) Q9DCF1
Entrez Gene ID: (Human) 84866, (Rat) 689172, (Mouse) 71687